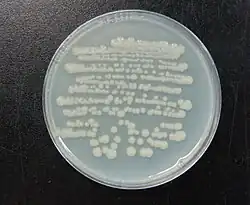

Duganella
| Duganella | ||
|---|---|---|
![]() | ||
| Taxonomía | ||
| Dominio: | Bacteria | |
| Reino: | Pseudomonadati | |
| Filo: | Pseudomonadota | |
| Clase: | Betaproteobacteria | |
| Orden: | Burkholderiales | |
| Familia: | Oxalobacteraceae | |
| Género: |
Duganella Hiraishi et al. 1997 | |
| Especie tipo | ||
| Duganella zoogloeoides | ||
| Especies | ||
Duganella es un género de bacterias gramnegativas de la familia Oxalobacteraceae. Fue descrito en el año 1997. Su etimología hace referencia al microbiólogo americano P. R. Dugan.[1] Son bacterias aerobias o anaerobias facultativas y móviles por uno o varios flagelos. Son mesófilas, con temperaturas óptimas de crecimiento entre 24-30 °C. La mayoría de especies se han aislado de agua de río, pero también de suelos y de algunas plantas.
Historia
Las cepas originales fueron aisladas de un filtro en el año 1967 y se identificaron como Zoogloea ramigera. Estudios posteriores observaron que estas cepas presentaban diferencias respecto al resto de cepas de esta especie, y se propuso su separación para formar el nuevo género Duganella.
Taxonomía
Actualmente hay 17 especies descritas de Duganella:[2]
- Duganella alba
- Duganella aquatilis
- Duganella callida
- Duganella dendranthematis
- Duganella fentianensis
- Duganella flavida
- Duganella guangzhouensis
- Duganella lactea
- Duganella levis
- Duganella margarita
- Duganella phyllosphaerae
- Duganella qianjiadongensis
- Duganella radicis
- Duganella rivi
- Duganella sacchari
- Duganella vulcania
- Duganella zoogloeoides
Sensibilidad antibiótica
Aunque no se ha descrito ninguna especie patógena ni causante de infecciones, en algunas de las especies se ha realizado estudio de sensibilidad antibiótica. Todas ellas coinciden en que son sensibles a amikacina, gentamicina, kanamicina, neomicina, doxiciclina y ciprofloxacino, y resistentes a oxacilina y clindamicina.
Referencias
- ↑ Hiraishi, A.; Shin, Y. K.; Sugiyama, J. (1997-10). «Proposal to reclassify Zoogloea ramigera IAM 12670 (P. R. Dugan 115) as Duganella zoogloeoides gen. nov., sp. nov». International Journal of Systematic Bacteriology 47 (4): 1249-1252. ISSN 0020-7713. PMID 9336937. doi:10.1099/00207713-47-4-1249. Consultado el 6 de enero de 2023.
- ↑ «Genus: Duganella». lpsn.dsmz.de (en inglés). Consultado el 6 de enero de 2023.
